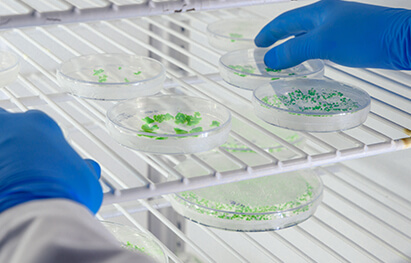

Q-Bio会议
7月26日至29日,第18届Q-Bio国际定量生物学会议(下称“Q-Bio会议”)在深圳光明云谷国际会议中心举办。来自美国、英国、印度等全球230多位研究学者齐聚本次盛会,围绕“复杂生命系统的定量规律与可预测模型”主题,深入探讨定量生物学和合成生物学领域的发展前景与潜在机遇。

▲参会者合影
本次会议由中国科学院深圳先进技术研究院、深圳理工大学、北京大学、深圳合成生物学创新研究院、深圳市合成生物学协会等多方联合主办。
继第17届会议成功举办之后,今年Q-Bio会议再次在深圳召开。地方组委会由中国科学院深圳先进技术研究院副院长、深圳合成生物学创新研究院院长刘陈立研究员领衔。

会议伊始,刘陈立在致辞中表示,感谢Q-Bio国际组委会今年再次选择深圳——这座有“中国硅谷”美誉、以科技创新著称的城市,而会议举办地光明科学城正迅速发展成科学研究与技术创新的国家级中心。深圳先进院囊括了9个研究所,聚焦信息技术(IT)和生物科技(BT)的交叉融合。其中,定量合成生物学蓬勃发展,学术社区也在急剧扩张,已构筑起极具规模的科教与产业高地。今年,依托深圳先进院的科研资源和产教资源,深圳理工大学作为一所新型研究型大学在光明区正式去筹成立。希望大家享受并深度参与到Q-Bio 2024这一场变革之旅,一起探索定量生物学的新境界。

本次大会由深圳先进院研究员戴磊主持。他介绍,Q-Bio会议为全球定量生物学专家、青年学者提供了一个探讨学科前沿进展、促进跨学科国际合作的平台,期待与会者们一同推动知识与资源的共用共享,促进科技创新,共同面对和解决全球性的科研难题和挑战。
现场,报告嘉宾们分别就合成生物学、系统生物学、人工智能、衰老、肿瘤、分子进化、微生物组等前沿话题进行分享,内容涵盖最新科研成果,以及各自领域的未来发展方向和潜在应用前景。现场反响热烈,跨学科的提问交流为整个会议增添了浓厚的学术氛围。

大会特邀嘉宾美国斯坦福大学教授James E. Ferrell对本次会议演讲主题的丰富性给予了高度评价。他提出,研究者们如何预测性地设计基因线路中的行为,仍是个悬而未决的问题。该会议为偏好定量方法的学者提供了宝贵的知识和启发,期待定量生物学的未来走向。

“深圳在定量生物学领域展现出了极高的活力!”中国科学院院士、西湖大学讲席教授汤超认为,深圳正逐渐发展成为定量生物学、合成生物学等前沿科技领域国际交流的中心城市,期望能有更多的年轻学者能够投身于跨学科的合作之中,保持思维的活跃性,在自由开放的学术氛围中追求自己认为有意义且渴望从事的事业。
来自威斯康辛大学麦迪逊分校的助理教授Scott M. Coyle表示,定量的手段把生物学从一门基于观察的科学变为真正具备预测能力、帮助人们理解生命系统的工具。通过这次机会,他看到了深圳正在建设的合成生物研究重大科技基础设施,以及正在进行的一系列前沿项目,这种“未来已来”的感觉让他备受鼓舞。

本次会议组委会成员、深圳先进院研究员魏平表示,定量生物学作为研究复杂生物系统的前沿交叉科学领域,亟需广泛、高效的国际合作,汇聚全球智慧,共同推动定量生物学重大科学问题的解决。定量生物学的发展,将促进复杂生命系统中多维度的精确测量、计算与数学工具、生命过程的本质理论、高通量标准化数据等的突破,帮助从原理上理解生命系统复杂功能的设计原则,推动从认识生命到设计生命的发展。
Q-Bio 2024 CONFERENCE
据了解,Q-Bio会议于2007年由洛斯阿拉莫斯国家实验室和美国新墨西哥大学两所科研机构的研究团队联合发起,已在全球范围内成功举办了18届,在生物物理学、系统生物学等领域具有高度声誉和广泛影响力。据悉,本次会议将与Quantitative Biology期刊合作开设专刊,会议所有录用稿件均有机会采用开放获取的模式出版。








左右滑动查看更多
Q-Bio2024会议的圆满落幕,凸显了深圳在全球科研合作特别是定量合成生物学领域的布局与愿景。定量生物学作为前沿交叉学科,其先进的测量手段和理论建模为揭示生物系统的设计原理和运作规律提供了强有力的工具。本次会议展示了深圳作为开放窗口和科技前沿城市的形象,对国家战略需求和科学前沿的重大问题进行了深入研讨,促进了源头创新和前沿交叉,为深圳建设合成生物学高地的战略目标注入了新的动力。

来源:合成所
责编:赖素麒
审校:孟倩羽、张赢、丁宁宁

安各洛(深圳)生物科技有限公司 版权所有